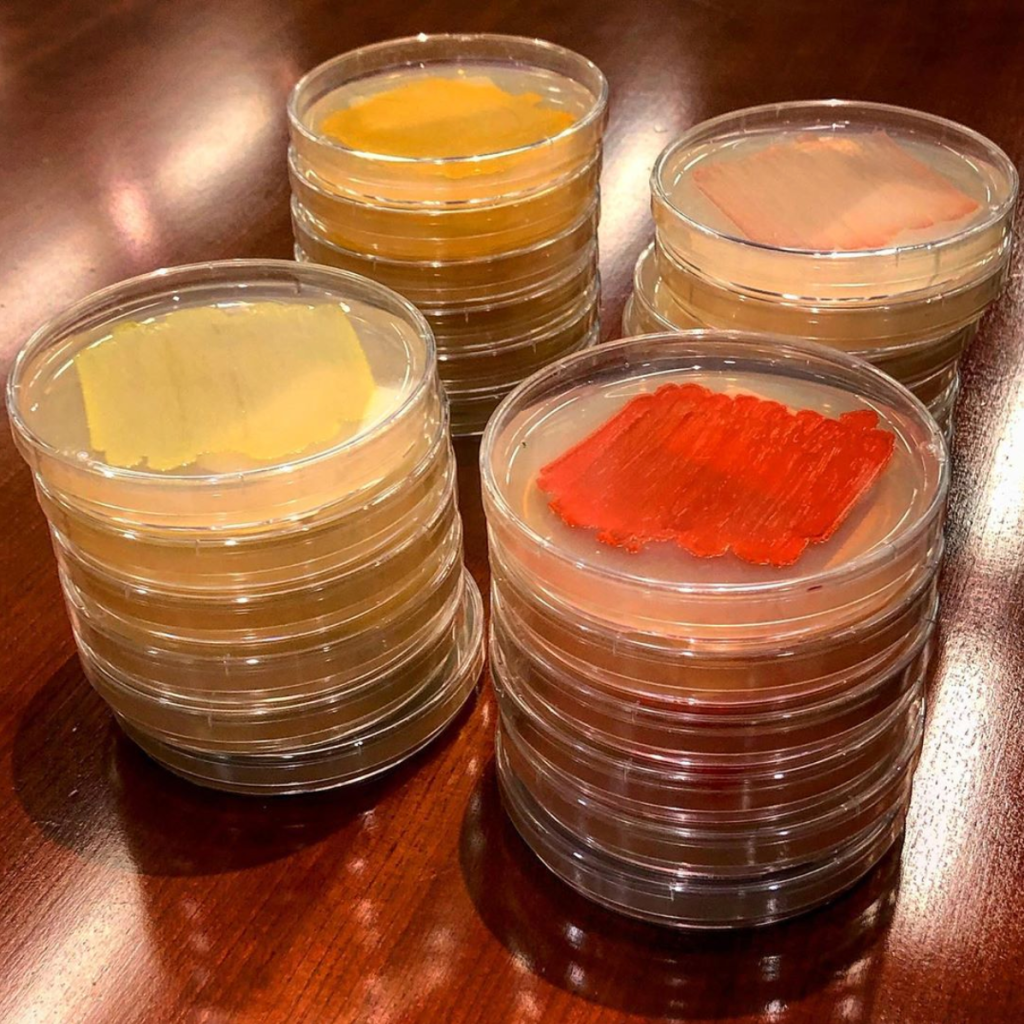

Julie Marie Wolf
Simplifying Science
Portfolio
A collection of written, audio, and video materials I’ve created about science + scientists.
Workshops

Where I’ve helped scientists to better communicate and taught workshops tailored to audience needs.
Musings

Unfiltered thoughts on the latest scientific research, communication platforms, and audience targeting.
If you talk to a man in a language he understands, that goes to his head. If you talk to him in his language, that goes to his heart.
Nelson Mandela
Effective communicators meet the audience where they are.
I add audience-specific contexts to new information that increases fact retention and long-term comprehension.
About Me
I’m a Ph.D. scientist who loves talking about + teaching others to talk about science. I previously worked for the American Society for Microbiology and Genspace, and now I work at IndieBio NY.
Get In Touch
- Email: juliewolf24@gmail.com
- Twitter: @juliemariewolf